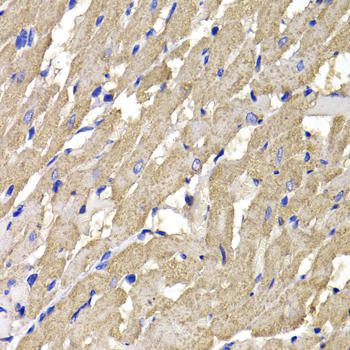
Anti-MPI Antibody (CAB7319)

Frequently bought together:
Description
| Antibody Name: | Anti-MPI Antibody |
| Antibody SKU: | CAB7319 |
| Antibody Size: | 20uL, 50uL, 100uL |
| Application: | WB IHC IF |
| Reactivity: | Human, Mouse, Rat |
| Host Species: | Rabbit |
| Immunogen: | Recombinant fusion protein containing a sequence corresponding to amino acids 1-423 of human MPI (NP_002426.1). |
| Application: | WB IHC IF |
| Recommended Dilution: | WB 1:500 - 1:2000 IHC 1:50 - 1:200 IF 1:50 - 1:100 |
| Reactivity: | Human, Mouse, Rat |
| Positive Samples: | Jurkat, HepG2, HeLa, SW620, Mouse heart |
| Immunogen: | Recombinant fusion protein containing a sequence corresponding to amino acids 1-423 of human MPI (NP_002426.1). |
| Purification Method: | Affinity purification |
| Storage Buffer: | Store at -20'C. Avoid freeze / thaw cycles. Buffer: PBS with 0.02% sodium azide, 50% glycerol, pH7.3. |
| Isotype: | IgG |
| Sequence: | MAAP RVFP LSCA VQQY AWGK MGSN SEVA RLLA SSDP LAQI AEDK PYAE LWMG THPR GDAK ILDN RISQ KTLS QWIA ENQD SLGS KVKD TFNG NLPF LFKV LSVE TPLS IQAH PNKE LAEK LHLQ APQH YPDA NHKP EMAI ALTP FQGL CGFR PVEE IVTF LKKV PEFQ FLIG DEAA THLK QTMS HDSQ AVAS SLQS CFSH LMKS EKKV VVEQ LNLL VKRI SQQA AAGN NMED IFGE LLLQ LHQQ YPGD IGCF AIYF LNLL TLKP GEAM FLEA NVPH AYLK GDCV ECMA CSDN TVRA GLTP KFID VPTL CEML SYTP SSSK DRLF LPTR SQED PYLS IYDP PVPD FTIM KTEV PGSV TEYK VLAL DSAS ILLM VQGT VIAS TPTT QTPI PLQR GGVL FIGA NESV SLKL TEPK DLLI FRAC CLL |
| Gene ID: | 4351 |
| Uniprot: | P34949 |
| Cellular Location: | Cytoplasm |
| Calculated MW: | 39kDa/46kDa |
| Observed MW: | 47kDa |
| Synonyms: | MPI, CDG1B, PMI, PMI1 |
| Background: | Phosphomannose isomerase catalyzes the interconversion of fructose-6-phosphate and mannose-6-phosphate and plays a critical role in maintaining the supply of D-mannose derivatives, which are required for most glycosylation reactions. Mutations in the MPI gene were found in patients with carbohydrate-deficient glycoprotein syndrome, type Ib. Alternative splicing results in multiple transcript variants. |
| UniProt Protein Function: | MPI: Involved in the synthesis of the GDP-mannose and dolichol-phosphate-mannose required for a number of critical mannosyl transfer reactions. Defects in MPI are the cause of congenital disorder of glycosylation type 1B (CDG1B); also known as carbohydrate-deficient glycoprotein syndrome type Ib (CDGS1B). Congenital disorders of glycosylation are metabolic deficiencies in glycoprotein biosynthesis that usually cause severe mental and psychomotor retardation. They are characterized by under- glycosylated serum glycoproteins. CDG1B is clinically characterized by protein-losing enteropathy. Belongs to the mannose-6-phosphate isomerase type 1 family. 2 isoforms of the human protein are produced by alternative splicing. |
| UniProt Protein Details: | Protein type:Carbohydrate Metabolism - fructose and mannose; Carbohydrate Metabolism - amino sugar and nucleotide sugar; EC 5.3.1.8; Isomerase Chromosomal Location of Human Ortholog: 15q24.1 Cellular Component: cytosol Molecular Function:mannose-6-phosphate isomerase activity Biological Process: GDP-mannose biosynthetic process Disease: Congenital Disorder Of Glycosylation, Type Ib |
| NCBI Summary: | Phosphomannose isomerase catalyzes the interconversion of fructose-6-phosphate and mannose-6-phosphate and plays a critical role in maintaining the supply of D-mannose derivatives, which are required for most glycosylation reactions. Mutations in the MPI gene were found in patients with carbohydrate-deficient glycoprotein syndrome, type Ib. Alternative splicing results in multiple transcript variants. [provided by RefSeq, Jan 2014] |
| UniProt Code: | P34949 |
| NCBI GenInfo Identifier: | 462567 |
| NCBI Gene ID: | 4351 |
| NCBI Accession: | P34949.2 |
| UniProt Secondary Accession: | P34949,Q96AB0, A8K8K9, |
| UniProt Related Accession: | P34949 |
| Molecular Weight: | 39,834 Da |
| NCBI Full Name: | Mannose-6-phosphate isomerase |
| NCBI Synonym Full Names: | mannose phosphate isomerase |
| NCBI Official Symbol: | MPI |
| NCBI Official Synonym Symbols: | PMI; PMI1; CDG1B |
| NCBI Protein Information: | mannose-6-phosphate isomerase |
| UniProt Protein Name: | Mannose-6-phosphate isomerase |
| UniProt Synonym Protein Names: | Phosphohexomutase; Phosphomannose isomerase; PMI |
| Protein Family: | Mannose-6-phosphate isomerase |
| UniProt Gene Name: | MPI |
| UniProt Entry Name: | MPI_HUMAN |
View AllClose
Additional Information
Product Type: |
Antibody |
Reactivity: |
Human |
Reactivity: |
Mouse |
Reactivity: |
Rat |
Host Species: |
Rabbit |
Isotype: |
IgG |
Antibody Type: |
Polyclonal Antibody |
Research Area: |
Cell Biology |